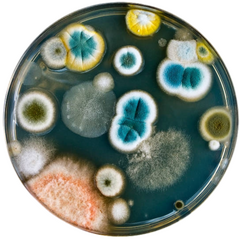
Untitled

amalgam corps, here for your displeasure
REST IN PIECES BUPZ/AMALGAM
died aprox. aug 20th 1999 ♌︎
❣❣❣🔞OUR CONTENT IS NSFW🔞❣❣❣
none of us are human
any pronouns
our brain is deteriorating...
☺ hypersexual deviant pervert ☺
polyam genderfuckfluid dykefag
‽ posic objectum fictosexual ‽
disabled retard schizo drug doer
♞ white boy from the US south ♞
i live in a big city now O.O scary!
⚧HRT-1/8/2025⚧
we like pokemon, neopets, webkinz, splatoon, digimon, plushies, and pooltoys the most currently. also we do art.
jack of all trades master of none.
this place is a real eyesore
no dni/byf if we fight we win
CONTENT WARNING : be prepared for anything and everything
this website will treat you better if you let it load all the way first...

if you think my site is neat you can link it on your own with this button!

SPACE AND TIME ITSELF BROUGHT US TOGETHER


MY SHOOTING STAR THAT FELL FROM THE HEAVENS ABOVE, YOU BRIGHTEN UP MY LIFE LIKE NO OTHER!
TAKE ME AWAY TO CLOUD NINE WHERE WE CAN WATCH THE SKY TOGETHER


TIME STANDS STILL WHEN IM WITH YOU. I WANT NOTHING ELSE THAN TO SPEND EVERY SECOND OF THE PRESENT WITH YOU...
I HOPE THIS MOMENT WILL LAST FOREVER


mew doesnt speak with human words but you know it loves you! myuuu!


are you here to see my babies? use your inside voice, they dont like loud noises. i am the nanny, ill be watching you... oh, and dont mind the cat, hes nice

ill take you to where it all begins...
PARTICIPATE IN THE GROWTH OF OUR SPECIMENS VIA MY TUMBLR FOR UPDATES. YOU CAN VOTE TO WATCH IT CHANGE BEFORE YOUR EYES!THE PURPOSE OF OUR HOMUNCULUS PROGRAM IS TO CAPTURE THE GROWTH OF THE EGO AS IT IS FORMED AND CHANGED BY THOSE SUPPORTING, COME BACK AGAIN IN THE FUTURE TO PAY TRIBUTE TO THE NEXT ITERATIONS OF ENTITIES...
There are currently 3 eggs incubating....Miaou


10/29/24
Scrap has been sleeping for what seems like weeks now, preserving its energy as it grows more and more… Its body seems to undulate briefly before it stretches out, revealing six small and stumpy nubs along its belly. Scrap is trying to waking up, but i think it still needs some time to cure…Its flesh is still quite tender and soft, as if it was born prematurely, or not meant to be born at all… Scrap very weakly lets out a small gurgling yip before curling back up and hiding its six new appendages under its tail…
HOMUNCULUS BIRTHED
10/13/24
SUBJECT : #01 - SCRAP
ORIGIN: MIRACULOUS
A SMALL WET BEAST THAT FITS PERFECTLY IN THE PALM OF YOUR HAND SITS BEFORE YOU, CURLED UP IN A PROTECTIVE BALL OF ITS OWN FLESH. IT IS SLEEPING SOUNDLY AND HAVING DREAMS OF DAYS FILLED WITH WARMTH AND ADORATION. IT SHUFFLES GENTLY IN ITS SLUMBER AND SMALL SQUELCHES CAN BE HEARD AS IT SHIFTS ITS BODY... ITS BEST YOU LEAVE IT BE FOR NOW. THINGS WILL BE CHANGING SOON ENOUGH...IT DREAMS TO SEE YOU...WHAT A LOVELY THOUGHT.



Just one rotten spot in your head can make every movement painful. You can't roll your eyes. bend down or jump and land with impunity. even thinking hurts. ⋆✴︎˚。⋆✴︎˚。⋆







nosy, arent you?
god tried to kill me three times, but things did not go how they wanted. sometimes the devil on your shoulder is right twice a day, his horns point in the direction of heaven.

my angels keep me safe though i am marked, the fortune of a rabbit with its lucky paw clamped shut in a beartrap. ive gnawed through my own haunch once. many paws run underneath me and i am constantly appearing in new places, though i have stationed temporarily. hermit by nature, forced into the spectacle of the world by myselves. trust us that the pastures have grown newly over the summers, it doesnt rain as much anymore. no more swamplands for me, but i still feel their eyes on my back.having you heard their wails before? that annual scream en masse wakes me every day, its ringing in my ears all the time and it gives me migraines...my head hurts and i think i will return to the comforts of my nesting... goodnight.

you're insatiable, huh?
and on some strange level i do believe i am entitled to everything including getting punched in the face to reciving undying adoration. revenge and an apology. recognition for suffering and the permission to let go. nothing is as comfortable as it used to be. my lungs dont fill with air like they used to. church is no longer magic and waking up is just a hobby now. i still want everything: the embrace of a person who loves me in the exact right way but also dystopian landscapes as close to nature as we'ev ever been
BANG! POW!! CRASH!!!




HEY...YOU AINT SUPPOSED TO BE BACK HERE!!!





THERE IS BLOOD AND VISCERA EVERYWHERE... THE ORGANS STREWN ABOUT SEEM TO STILL BE PULSATING WITH LIFE. THE BLOOD SEEPING DOWN THE WALLS NEVER SEEMS TO STOP. NOTHING HERE EVER TRULY DIES...BUT YOU CAN HEAR THE GURGLING OF UNFATHOMABLE GROTESQUE BEASTS APROACHING... YOUD BETTER START RUNNING...QUICK!! RUN!


it doesnt need to make sense to you


you only know what i want you to know
ALL-EMBRACING OMNEITY


to learn about the residents of bupzbie,
try clicking the icons below...
BARYOGENESIS BEDLAMITES
THE PRIMORDIAL OOZE


YOU DID IT!!
congratulations!!
if you've made it this far, i assume you've finished scouring this carrd up and down :) awesome!?!?
if you just skipped on past everything and ended up here somehow, though... hmm... that's disappointing, i guess...
either way it was nice having you here, thanks for entertaining my delusions for a brief moment <3you stay in here with me now ok? there is no way out ok?







come back again sometime and maybe there will be more adventures to be had dissecting my schema for future neuroscience studies
.:mAIN LAIRS:.->tumblr<-
->BLUESKY<-
->twitter<-
->furaffinity<-
->shop<-

LOVE ME FOLLOW ME
FOLLOW ME LOVE ME

LOVE ME FOLLOW ME
FOLLOW ME LOVE ME

CONGRATULATIONS!


WOW, THANKS SO MUCH FOR YOUR SUPPORT!! WE LOVE YOU!! ❤︎₊ ⊹❤︎₊ ⊹❤︎₊ ⊹YOUR OFFERING WILL BE GREATLY APPRECIATED BY THE HOLY POLYMORPH...

you've ascended!
"i have decided differently"
☹aw dang it...thats too bad!
that's alright though ˖⁺‧₊˚✦ no hard feelings ♡if you ever change your mind you can always come back :) i promise we don't bite...too hard, hehe!your presence itself is a welcome sight, may your path cross mine again in the future, i wish you well!!
have a nice rest of your day


silver


any pronouns
genderfuck bitchboy
full time paranoid schizoid freakmarried to my mind and lost in my encephalon pantheon. let your fingers feel over the gyri, and dig your nails into the sulci. claw into new fissures and expose my stem and feel what i feel. reach the bottom of me.i like rhythm games, collecting things, and blasting loud musicautoassassinatophile
the precipice
genesis gemini
omphalos ->ouroboros<-
->🧠my brain twin🧠<-
refractions of raw sketches of pleasure
being seen is actual self-mutilation

what are some of the ways you've died?

if i dont make things the voices will win...
.:BIGGEST WIPS CURRENTLY:.
• 3 rpg maker games
• table top war game w/ rpg elements
• ps2 style fantasy collectathon
• interactive horror arg
• visual novel set in medieval times
• website to host it all
JUST ONE BITE...JUST ONE BITE...JUST ONE BITE...


KIN/ID

silver - pokemon

brian pasternack - yuppie psycho

dwight - dead by daylight

crona - soul eater

casanono - yokai watch

eevee - pokemon
F/O💞

arven - pokemon

sasha nein - psychonauts

misa amane - death note
3...2...2...2...1...
THE OUROBOROS SUBSYSTEM
SILVAS
any pronouns
vacant vessel
the passim
immaterial husk





shed prototype
everything balances itself out in one way or the other. just be patient now...okay?
~let bygones be bygones
red stains on blue hoodies dont make purple hearts

jessilyn
mx. jess or jessie
lecherous basilisk
she/her 🐍 ♂

the umpire
PA and receptionist
est. 2020
💲boss man💲grade A quality venom
"Swallow your anger. Pretend!"

What once was our palace...


૮₍ ˶• ˔ ต ₎ა
clipped in 2012
-` (:̲̅:̲̅:̲̅[̲̅:♡:]̲̅:̲̅:̲̅:̲̅) ´-
VASILEOS
₊✩‧he/buns/hops₊✩‧
₊˚♡‧⁺housepet₊˚♡‧⁺
the sycophant
⋆。‧˚ʚɞ˚‧。⋆
sacrificial kit
✧˖°⊹ ࣪˖⊹ ࣪ ˖✧˖°

Exalt yourself, and dream with me


infected in 2022


SILENT
no pronouns - neutrois
the penetralia
gutted viscera

locked up in a padded cell
lost the key to our straitjacket and muzzle
nothing is clean...
-ˋˏ✄┈┈┈┈
"Blows that wound cleanse away evil; strokes make clean the innermost parts"
-Proverbs 20:30

🦇🌙RUSSILL🩸🐺
︶꒷꒦︶ ๋࣭ ⭑
ze/zyr-it/its
strigoi pricolici
the runt
somepuppy has got to start
using his big boy bark, haha!
collared and tamed 2015

pssst, hey!
pssssst, yeah -you!
mind lettin' me nibble yer ear for a minute?
◤

◤




lusille
sometimes goes by silly, we jest...any pronouns / genderflux
the hellequin - pyrococcus radge
i trained rosie

is there a part of your body that is more real than the others? could you demonstrate that realness?


Faisil
dae/daem - he/him
concubus
presentable and well groomed
he was a disgusting thing- a creature under the hand of god but somehow the way he cries was so sad i wanted to give him a flower. it was raining and he was losing his blood, he was losing his brain, in a cold place, in a ditch, and i told him he was going to die, and it was true. as he did, his face twisted into a frown, like a devil.

(surely there must be something to gain from this.
something of value, yeah?... well, at least we had fun.)
v

the cambion - snakebitten bastard
sold my soul to the devil in 2017
Mother, please forgive me
I just had to get out all my pain and suffering
Now that I am done
Remember I will always love you
I'm your son
ROSILEE OR ROSIE
they/them - demiboy
sulky selkie
the desolate

free since 2023

i can do tricks!!! i promise im good!

lets play in the snow together!
otherkin satanist juggalo furFAG
widdiful sadomasochist freak zombie
i live in the clouds, & magic is real!! ok?
i am a deity of love, lust, & indulgence!!
agathokakological eleutheromaniac

he/buns/it/aer
WOLPERTINGER LOVERBUNNY OF YOUR FANTASIES COME BACK TO LIFE!!
THE fescennine - genesis gemini
kairos utopian - implanted entozoan
->🧠my brain twin🧠<-

IS THIS WHAT YOU WANTED?
¿ARE YOU HAPPY WITH YOURSELVES
SECRET KINNIES PAGE
benny (lego) lolz & rofl (charlie the unicorn)
aiai (super monkey ball) gir (invader zim)
eevee & pikachu (pokemon) potato (pui pui molcars)
tokomon (digimon) happy bunny (happy bunny)
hamsters, monkeys, rabbits, ghosts






Cynder
SIE/SIER - omnigender
a dragon trapped inside this body,
i am spreading my wings now.you had a purpose before anyone had an opinion.
the zburător
echoed umbradrakebound & mystified
elements mastered
•SHADOW •FEAR •WIND •POISONi wage war with myself and i will destroy myself, or i will be reborn, that is all.

:) yay! DIGIMON, NEOPETS, WEBKINZ, CARD GAMES, VIOLENCE, DISMANTLING THINGS UNTIL THEIR GUTS FALL OUT!!!>:( NAY! losing in games, being patient, recharging



kins;
wayne - hylics
shin - dorohedoro
daan - fear and hunger
edward elric- fullmetal alchemist
bob cat, lynx, gorgonopsid, thylacine





get on your knees, and dont just pray to the angels above, scream. let them know how much you ache.
ICARUS
or icky for short 💜
any pronouns - genderfluid dykefag
i'll be whatever you want me to be ;)
sacrilegious angel +otaku +nympho
the hallowed
heretic messenger
god raped me




HEXXUS

THERE IS AN IMPORTANT DISTINCTION THAT MUST BE DRAWN BETWEEN THE WORDS DISSECTION AND VIVISECTION. A DISTINCTION THAT WOULD APPEAR TO BE LOST ON YOU. YOUR PURPOSE WAS TO LISTEN AND YET AT EVERY TURN YOU HAVE PRIED, YOU HAVE PRODDED AND YOU HAVE INTERFERED. HAVE YOU NOT BEEN PAYING ATTENTION? DID IT NOT OCCUR TO YOU THAT AS AN ORGANISM EXISTING WITHIN A GREATER ORGANISM, YOUR INTRUSION WOULD BE FELT? AND STILL YOU HARASS. AND NOW, LIKE THE WAYWARD SPIDER WHO WITLESSLY SETTLED ON A SLEEPERS TONGUE, YOU WILL BE SWALLOWED. BECAUSE THE TRUTH IS THIS. WHEN A HOUSE IS BOTH HUNGRY AND AWAKE EVERY ROOM BECOMES A MOUTH.
IT/ITS ONLY
AGENDER ASEXUAL

so not in the fucking moodim still here for her and her only

the emaciated
snuffed carcass
injected values

dont look at me, dont talk about me. if anyone asks, youve never heard of me. push my existence from your mind and allow me to revel in anonymity.



lawrence/ten
any pronouns idc
androgyne girlboy
none of this matters
the revenant
putrefied drudge
i enjoy taxidermy, invertebrate zoology, slasher/splatter horror, metal music
i love my cats & basil

Brandy

Fluttershy

Czernobog

Royale

Sunspot

Lapis

Lilac

Blitz

Jemma

Darla

Jim Skivvies

Maizie

Almond

Peat

Harpy


Cavity

Xenia

Astora

Parallax

Monty

Lovelace

Richmond

Racing Stripes

Bumble

Sicko

Coldwave

Stulmass

Cero

Damascus

Aspen


Rylee

Double

Flitter

Beetlynn

Salt

Miss Ma'am

Skree

Chuck

Psycho

Mythos

Remedy

Pebbles

The Beast

Mr. Whiskers

Iggy

Moomin


Dakota

Enigma

Orion

Jynx

Comet

Mothrine

Onyx

Trouble

Excalibur

Gadget

Spectre

Pickle

Nugget

Slate

Trapper

Marble

Mysti



love is a little different from the average day to day activity. it's mostly a kind of "recreation"...



CALLIE ;3
SHE/THEY/IT/PETS
CATGENDER FURREAK
i've got more than 9 lives, kitten!
enchanter.
siren.
coquette.
plaything.
kitten.
murderess!!!
the misbegotten
CURRENTLY CAGED
CALIFORNIA CALICO
HYBRID CATGIRL


Eight
they/it
the awakened
defective unit
grown in a lab
not all there
prefers typing over talking
i watch over flipper

Andrian
he/they ♡ nonbinary♂
somnolent soother drake

♡flowers & nature walks
♡arts & crafts
♡animal husbandry
♡rock collecting



stray
pup/pups - good boythe empyrean
vagrant cosmonautthe stars that shone have all gone out as man betrayed your trust, but your spirit is still in place somewhere, out there in space.listen to star dust. trust your fear.


HE/HIM ♂
THE BOOKWYRM - CADET GREENHORN
ADMINISTRATOR - WARDEN
I COLLECT DATA AND KEEP FILES SAFEIM BUSY IN MY STUDY, PLEASE LEAVE!!



DELTA
he/they nb
BUTCH OTTER DYKE
the dogmatic
micawber hesperus

KAZOO
he/him ♂
gnc frog prince
aquarist & aquaphile
squeaky clean conscious
-outspoken -blunt
-clean -orderly



STARLING MURRMURR

the nebulous
transient leviathanholy grail inflatables;
💦brand; frenry "loch mess monster" 1986-1987
💦brand; intex sand n sun "whale ride on with babies" walmart exclusive
💦brand; puffypaws "pink bunny float" 2015
💦brand; bravostar "giant bull pool float"

MACKEREL/KRAKEN
he/it
i am fixated on subnautica and vinyl inflatables

thanks for swimming with me today, see you next summer.


.:CRY:.

he/him - bugboy
the sequestered
burrowed grubling


do you know where you are?
no, sorry...
that's okay stay as long as you need. we will keep you company.
thank you, but what is this place? i need to get home, i think...
does that matter? time is stagnant here, and no time spent with a friend is wasted. it's okay to relax.
i suppose i could spare just a moment to catch my breath...
mae
she/they
dyke
the musing
hushed
nostalgia

FLIPPER




PEST
ZE/HIR

LOCATED AT THE LAB
THE ALCHEMIST
PERVERSE PLAGUECAN I SEE WHAT YOUR INSIDES LOOK LIKE?
MINE ARE ROTTEN

LUCAN
Lucanus cervus ♂
dae/he dragon beetle
the vagabond
corpulent coleopteran

i like renovation, building, putting things together, puzzles, and bugs
i look after : this grub

BYTE

it/he
bzzrrt... subject: missing
recalculating...bzzt.
the visitor
otherworldly entity
bzt...lets get going: onward!
so-so-so much to - bzzt - do...
now loading...

ERROR
<-DISMISSED


MARLOW
the raw ... fragmentary enigma


why did you
do that?
the experience
also known as: exp.
it/he - kéntauroi shesepankh

the revelation
oracle sphinx
the door isnt locked, its just closed. it's ready when you are.
i'll be waiting for you to spill your heart...it all starts with you first.
inah

the girl . she/her
Ascended Goddess
agelessput on this plane unwilling,
your existence signed away
before you were even conceived
this is your place now, you know it all too well. you cant escape, get used to it.


CHEAT
HY/HYM.
YOUR DESIRE & YOUR FEAR OF DESIRE ANNIHILATE EACH OTHER.

TO FEEL COMFORTABLE IS TO GET COMFORTABLE WITH THE UNCOMFORTABLE


KEVIN 11
he/xe/it

THe MALESUETE
sardonic misfit
naturally unnatural
daddy issues haver
alien in a human suit

we've started over (again), our new reality, our new memories, our new bodies... and we'll get it right this time
ISLAND OF FOXES ; USER PROFILES
ASSETS HAVE BEEN IN STORAGE FOR OVER A MILLENNIUM; SOME DATA MAY BE CORRUPT

FIRST LIEUTENANT LAVVI RULER OF THE 2000s
the island had been hidden away in the clouds for many years, but now those clouds choose to part for us.
foxes keep the rabbit population in line, we have always been here. always hungry, always waiting.



amorphous shibboleth
the deposit

foundational to the preservation of the system
۶•ৎim special۶•ৎ




pentamerous point
peaking my snout out of the depths to look at you
-`✮´-
shi/hir
a piebald european red fox who is actually quite blue...ʚ internet faerie ɞ



WIDE USE OF APPLICATION WHEN DOWNLOADED PROPERLY~
come in closer, we dont bite... the draugr have been telling me all about you :)


VIVI
lance corporal of laviniaaroace-she/her



one day that little girl may find a filthy metal spike and drive it right in the middle of your forehead.
for she and her friends, this is very, very good, but for you the game is over.
the trogoautoegocrat
shepherd of sins


I think you're a joke, but I don't find you very funny



the maudlin
💙intimate agony💚

EVERYTHING I WANT WANTS ME MORE


harsh...
LIU
SHI/HYM




AVA


SHE/HIR
THE EVANESCE
AXIOMATIC MORIBUND

AUT VIAM INVENIAM AUT FACIAM
I AM A SYMBOL OF ORIGINAL SIN.
I KNOW WHAT GOD KNOWS.





FRENZY

ze/zyr/zyrs ☣︎ ax/axe/axes
nonhuman agenderfluid✧˖°.
...


I ACCEPT THAT SACRIFICE SIGHS & CUMS LIKE AN ANGEL
I ACCEPT THAT I WILL BURN IN HEAVEN WITH YOU


⚫genderless ⚫it/its
⚫xxx ⚫xxx ⚫xxx
nepenthe kalopsia
the selcouth